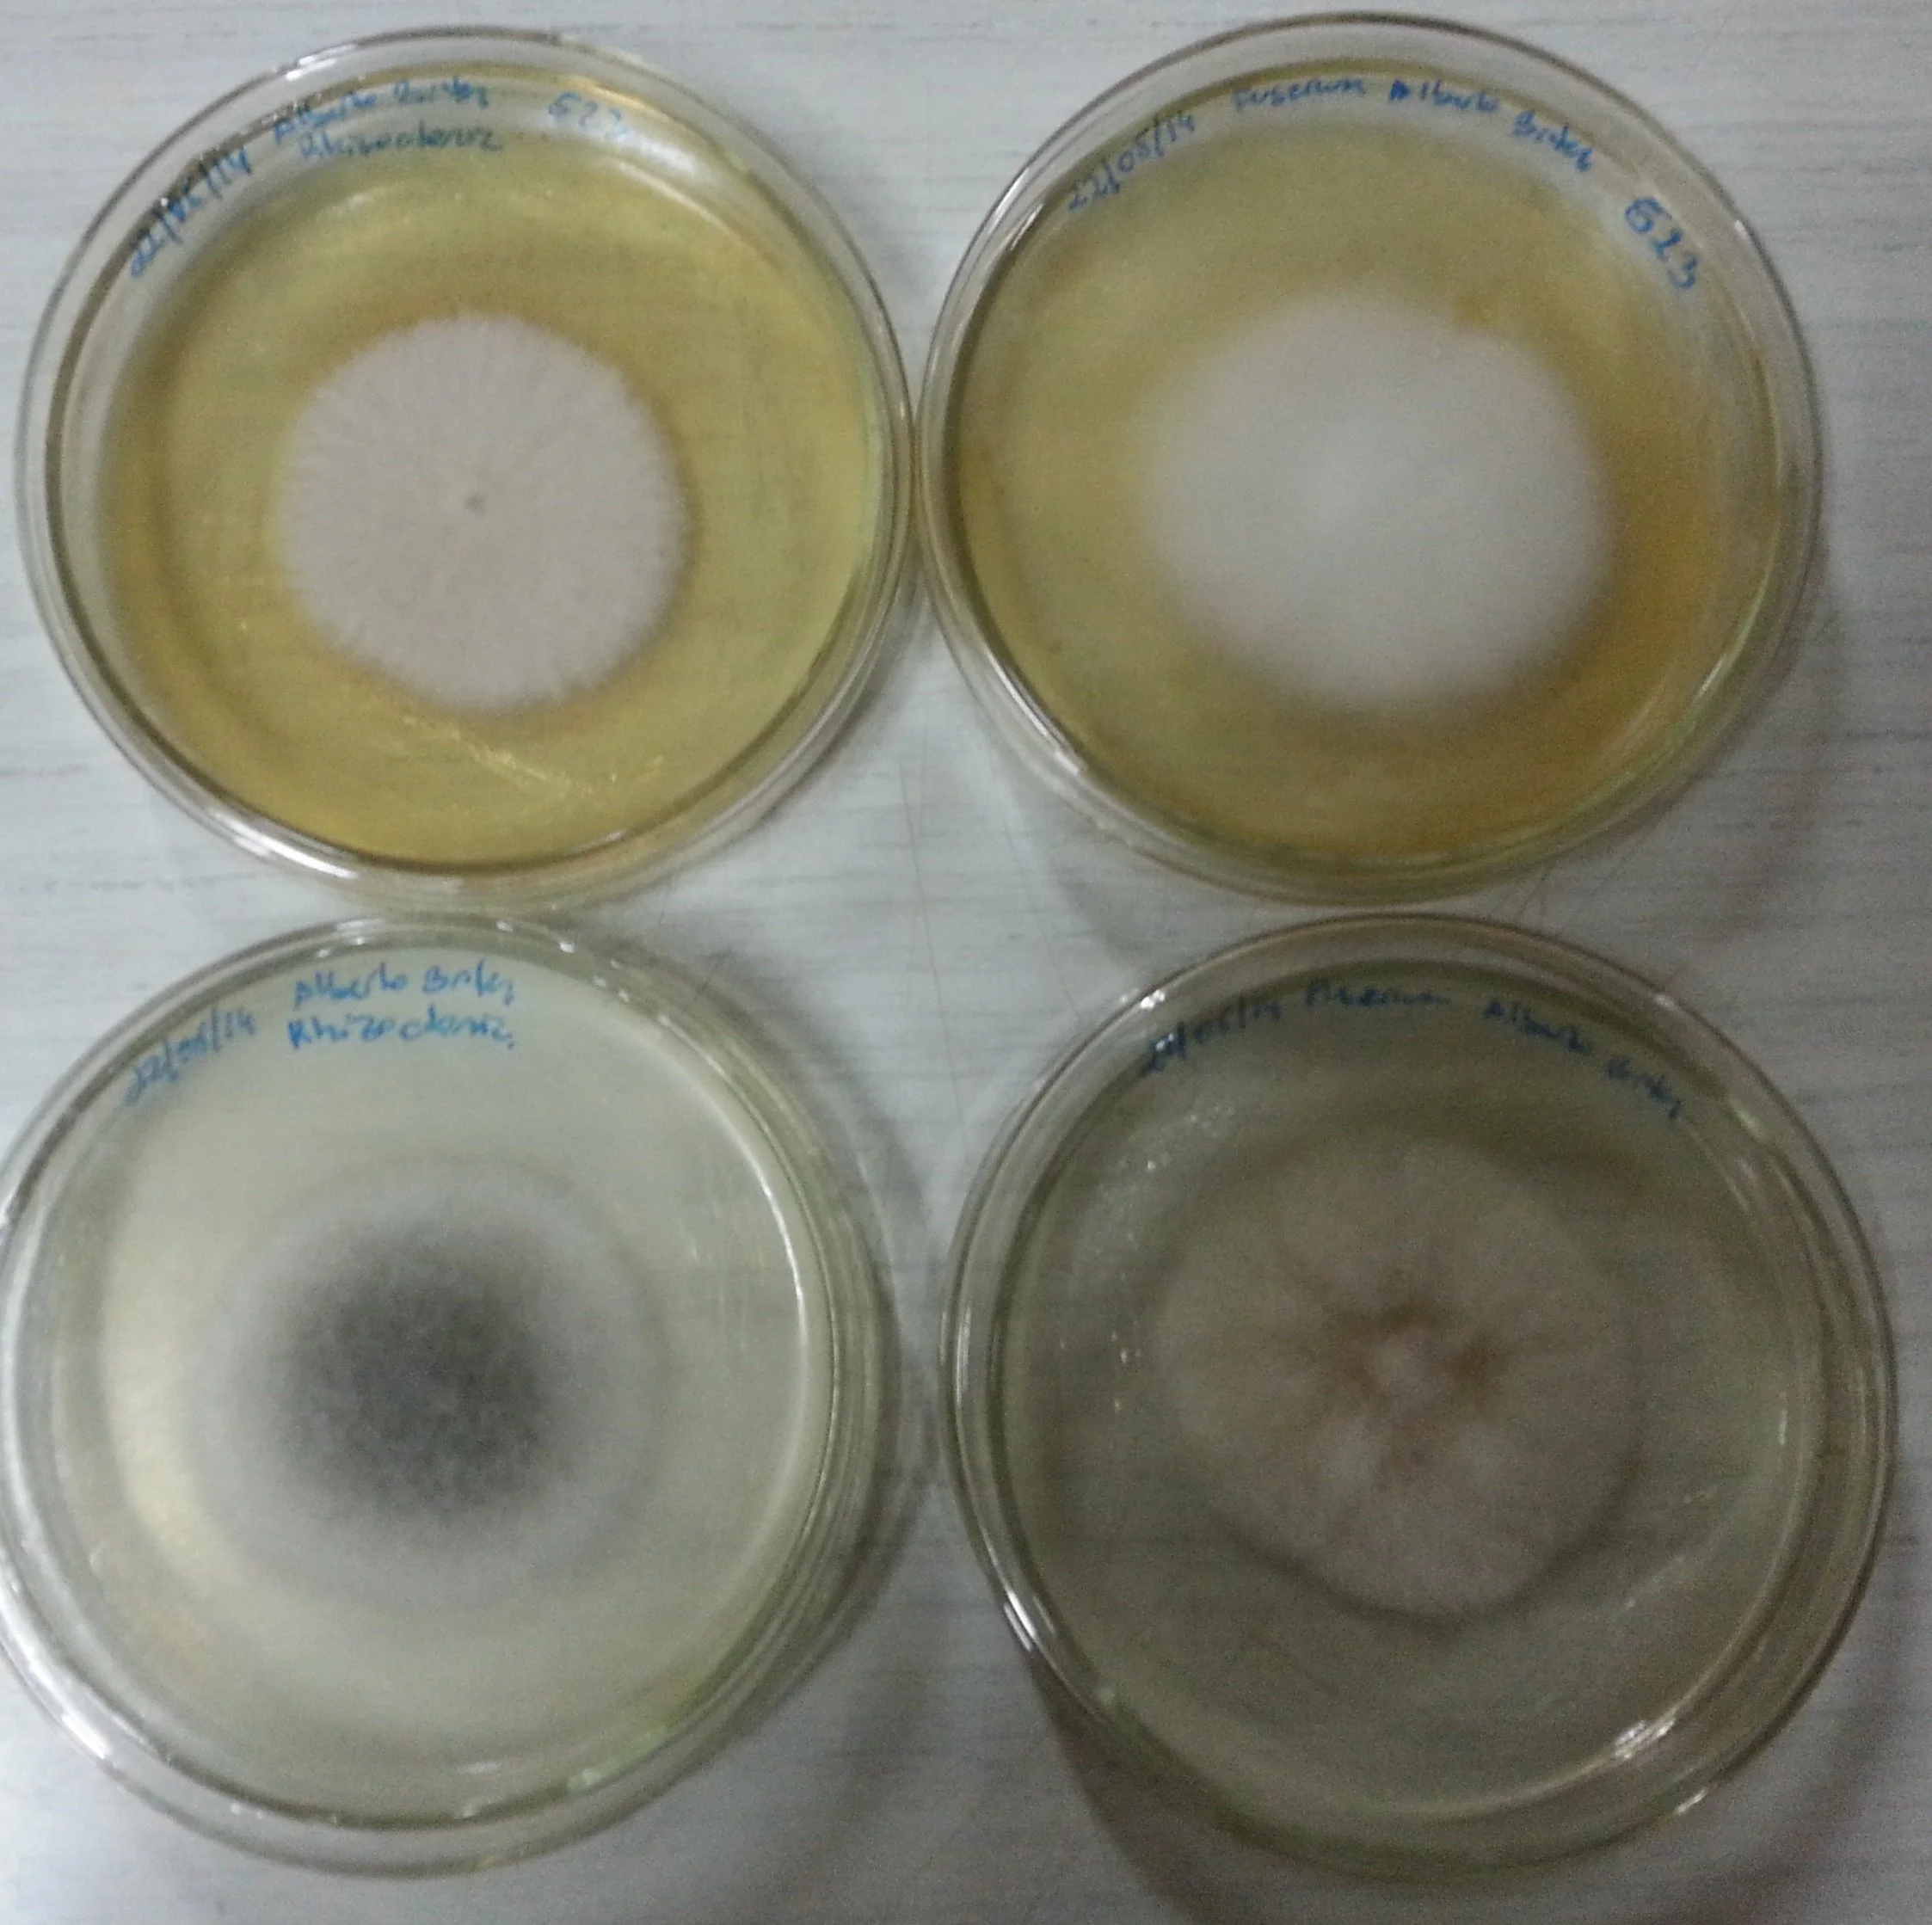

ALBERTO BRITEZ
Paraguay ExperienceIntegrated Pest Management
Crops
Paraguay ExperienceParaguay ExperiencePeople
Paraguay ExperienceIntegrated Pest Management

Crops










Paraguay ExperienceParaguay ExperiencePeople






